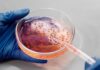

Últimas entradas
Lo Relevante
TEXTO ÍNTEGRO: CALENTAMIENTO del MAR continúa en aumento y tiende a...
El calentamiento de los océanos sigue aumentando y podría romper nuevos récords en los próximos meses, en medio del posible regreso del fenómeno de...
Copelas o CUELLO
Opinión. CARLOS RAMOS PADILLA.
De golpe recordé que Zhenli Ye Gon declaró que políticos mexicanos lo extorsionaron para que guardara en su casa,
en una bóveda...
SOBERANÍA y SEGURIDAD
En la antigüedad, la soberanía podría ser definida como "el poder absoluto y perpetuo de una república" que era ejercido por un soberano, llámese...
MORENA sí puede ser declarada ORGANIZACIÓN TERRORISTA
Opinión. FRANCISCO RODRÍGUEZ
Hay un pozo de engaños que está convirtiendo al Estado en ruinas, mientras pocos en su sano juicio se preguntan cuál es...
SINALOA, igual que antes
Opinión RAMÓN ZURITA SAHAGÚN
Nada cambió en Sinaloa con el relevo de gobernador. La salida de Rubén Rocha Moya solamente fue simbólica y los problemas...
CDMX en Punto
BASURA es responsable de ocho de cada 10 INUNDACIONES y desbordamientos...
En el inicio de la temporada de lluvias y ciclones, Citlalli Peraza Camacho, directora del Organismo de Cuenca Aguas del Valle de México (Ocavm)...
Punto de Encuentro
Dos COMUNIDADES de MICHOACÁN sufren tres días de ATAQUES ARMADOS
Ayer se cumplieron tres días de ataques armados de presuntos integrantes del cártel Jalisco Nueva Generación (CJNG) contra pobladores y autoridades tradicionales de las...
Política en Punto
SHEINABUM enviará al CONGRESO una reforma para crear la Comisión de...
Tras las acusaciones de Estados Unidos de presuntos apoyos del narco para que llegara a la gubernatura de Sinaloa Rubén Rocha Moya, la Presidenta...
Congreso
El CONGRESO FEDERAL busca ampliar las Causas de NULIDAD en la...
El Congreso federal busca ampliar las causas de nulidad de una elección agregando las 'injerencias del extranjero'.
La Comisión Permanente del Congreso aprobó ayer...
Economía
EU obligará a bancos a investigar, monitorear y reportar REMESAS de...
El Presidente Donald Trump emitió un decreto que obliga a bancos a investigar, monitorear y reportar remesas de los migrantes.
Pide revisar su interacción...
Energia en Punto
PEMEX tuvo mayores PÉRDIDAS a las que había reportado a los...
En 2018, 2020, 2021 y 2024, cuando el director de Pemex era Octavio Romero Oropeza, bajo el Gobierno de Andrés Manuel López Obrador, así...
Ciencia y Tecnología
AVIÓN de combate de EE.UU. DERRIBA un presunto OVNI, revela el...
El Departamento de Guerra estadounidense anunció este viernes la publicación de una segunda partida de documentos del Gobierno que documentan encuentros con Fenómenos Anómalos...
Ecología y Medio Ambiente
METEORÓLOGOS alertan de un 80% de probabilidad de que reaparezca un...
Hace 149 años, de 1877 a 1878, el clima de la Tierra se volvió loco sin que nadie lo viera venir, con lluvias e...
Punto G
Este es el TOP 20 de las CIUDADES más INFIELES de...
Hay muchas parejas que terminan a consecuencia de la infidelidad por alguna de las dos partes y de acuerdo con la aplicación de citas...